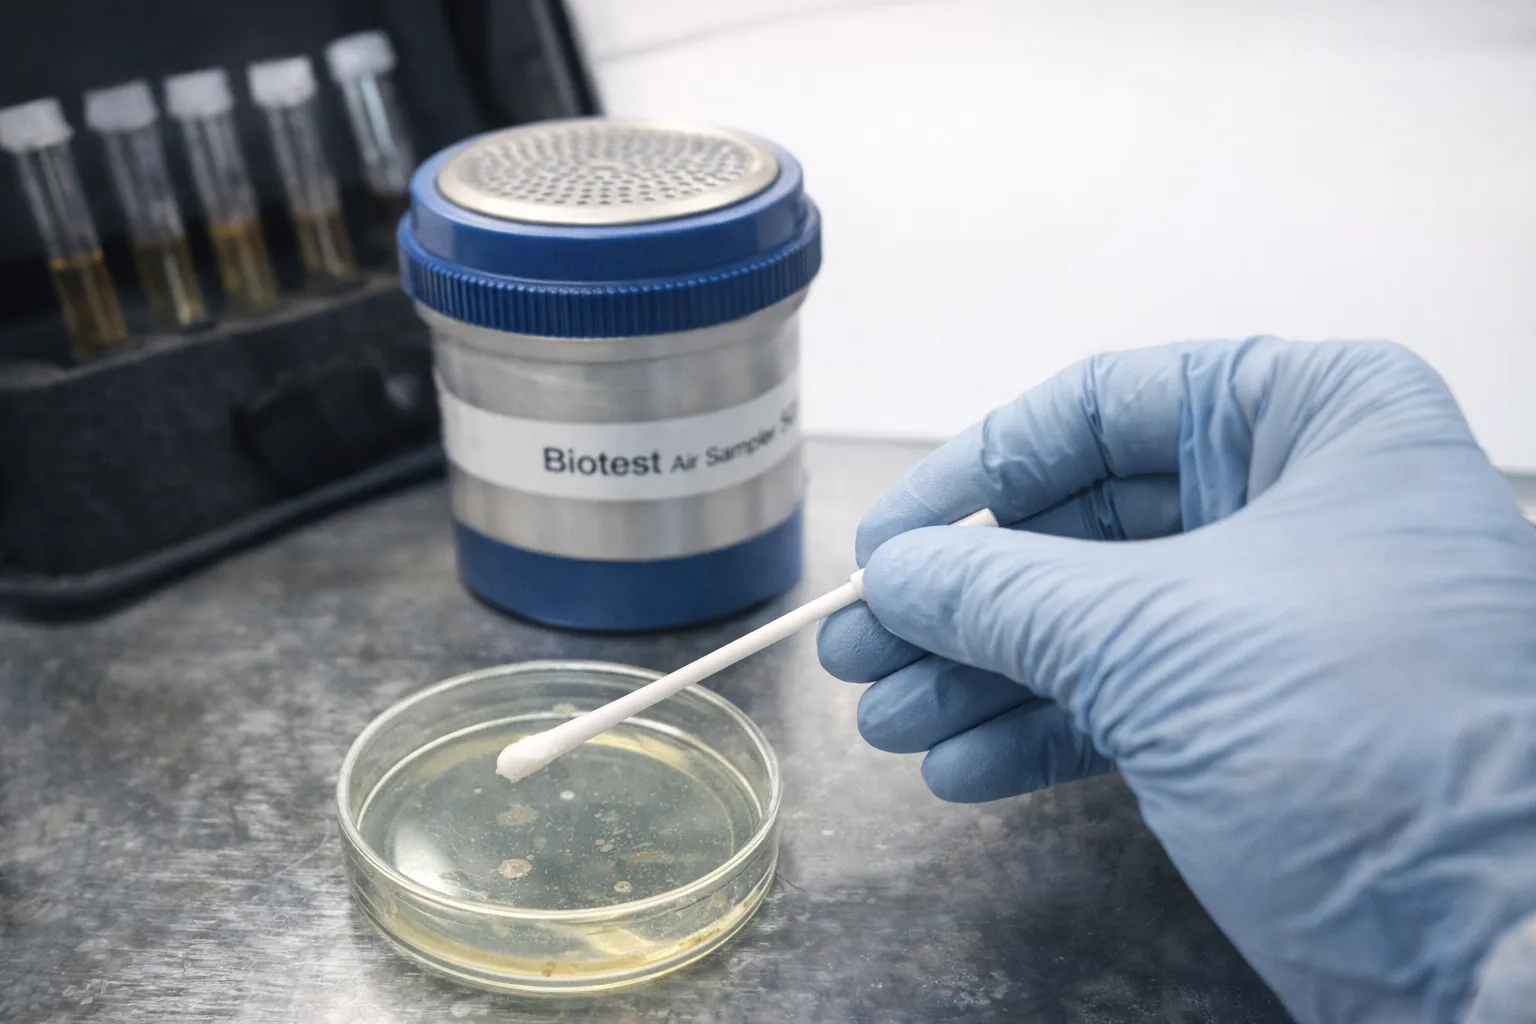

【食品工場のカビ再発に終止符】結露・胞子・建材内部に潜む見えないリスク
2026/01/25
目次
【食品工場のカビ再発に終止符】毎日掃除しているのにカビが減らない本当の原因とは?|結露・胞子・建材内部に潜む見えないリスク
「掃除不足」ではありません。食品工場でカビが再発する根本原因と、品質管理担当者が今すぐ知るべき対策視点
食品工場におけるカビ問題は、単なる「見た目の汚れ」では済まされません。
異物混入リスク、製品品質の低下、監査時の指摘、クレームや操業停止など、企業の信頼そのものに直結する重大な課題です。
特に品質管理を担当されている方の多くが、
「毎日しっかり清掃している」
「清掃マニュアルも守っている」
「それでも同じ場所にカビが出てくる」
と、強いストレスや疑問を抱えているのではないでしょうか。
私たちMIST工法🄬カビバスターズ東京にも、食品工場の品質管理担当者様から
「清掃業者の問題なのか?」
「作業員の意識が足りないのか?」
「なぜ改善しないのかわからない」
といったご相談が数多く寄せられています。
しかし、はっきりお伝えします。
食品工場でカビが再発する原因の多くは、“掃除不足”ではありません。
問題の本質は、
・空中に漂う目に見えないカビ胞子
・温度差によって発生する結露
・壁や天井、床下など建材の内部に溜まった湿気
・換気や排気によって生じる負圧・空気の流れ
といった、日常清掃では対処できない領域にあります。
本記事では、食品工場で「なぜ掃除してもカビが再発するのか?」という疑問に対し、
品質管理担当者の立場で理解しやすい形で、原因と考え方を整理していきます。
さらに、一般社団法人微生物対策協会と連携した真菌検査(カビ菌検査)の重要性や、
MIST工法🄬カビバスターズ東京が現地調査で行っている
含水率検査・ファイバースコープ調査・風量計による負圧検査についても触れ、
「なぜプロによる調査が必要なのか」を明確にしていきます。
「これ以上、同じカビトラブルを繰り返したくない」
そう感じている方にこそ、ぜひ最後までお読みいただきたい内容です。
掃除してもカビが再発する食品工場の共通点
食品工場でカビが再発する現場には、いくつかの共通点があります。まず挙げられるのが「清掃は徹底している」という点です。床や壁、製造ライン、排水溝まで日常的に清掃され、記録も残されている。それでも、数週間〜数か月後に同じ場所、あるいは近接箇所に再びカビが発生する。この状況に、多くの品質管理担当者が頭を悩ませています。
重要なのは、清掃で対応できるのは「表面に現れた結果」だけという点です。カビは見えてから対処するのでは遅く、発生の前段階である「湿気」「空気の流れ」「胞子の定着環境」が整ってしまっているケースがほとんどです。食品工場は温度管理・洗浄工程・蒸気の発生などにより、一般建築よりも湿気が発生しやすい環境にあります。
また、設備更新やレイアウト変更の影響で、空気の流れが変わっていることも少なくありません。以前は問題なかった場所にカビが出始めた場合、その多くは建物環境そのものが変化しているサインです。掃除をどれだけ強化しても改善しない場合、原因は「清掃以外の場所」にあると考える必要があります。
【見えない原因】 空中を漂うカビ胞子
食品工場のカビ再発で見落とされがちなのが、空中を漂うカビ胞子の存在です。カビは目に見える状態になる前、すでに胞子として空気中に広く拡散しています。清掃で表面のカビを除去しても、空中環境が改善されていなければ、再び同じ場所に胞子が定着し、増殖を繰り返します。
特に食品工場では、換気設備や排気設備が複雑に配置されており、空気の流れが一定ではありません。製造エリア、包装エリア、原料保管エリアなどで気圧差が生じると、目に見えない胞子が移動・滞留しやすくなります。その結果、「発生源とは別の場所」でカビが見つかるケースも多くあります。
このような場合、表面清掃を強化するほど「なぜここに?」という違和感が増していきます。これは決して現場の管理が甘いわけではなく、空中環境を数値で把握していないことが原因です。一般社団法人微生物対策協会と連携した真菌検査(カビ菌検査)では、目に見えない空中浮遊菌の状態を把握し、再発のリスクを客観的に評価することが可能です。
【見えない原因】 結露がカビの温床になる理由
食品工場におけるカビ再発の大きな要因のひとつが「結露」です。結露は一時的な水滴に見えますが、実際にはカビにとって非常に安定した水分供給源となります。特に天井、配管周辺、外壁に近い壁面などは、温度差が生じやすく、知らないうちに結露が発生しているケースが少なくありません。
結露の厄介な点は、「乾いたように見える時間帯がある」ことです。日中は乾燥しているように見えても、夜間や稼働停止時に結露が発生し、これを毎日繰り返すことで建材内部に湿気が蓄積されていきます。この状態は日常清掃では把握できず、気づいた時にはカビが定着しているという結果につながります。
また、結露は空調設定や季節変化、設備の稼働状況によっても発生条件が変わります。そのため、「以前は問題なかった」という認識が通用しなくなるのです。結露対策を考える上では、見た目だけでなく、含水率検査などによって数値として水分状態を確認することが非常に重要になります。
【見えない原因】 建材の奥に潜む湿気とカビ
食品工場で再発するカビの中には、すでに建材の奥で進行しているケースが多く含まれます。壁の内部、天井裏、床下などは日常点検の対象外になりやすく、表面に異常が出るまで気づかれません。しかし実際には、結露や漏水、湿気の滞留によって、内部でカビが繁殖していることがあります。
この状態で表面清掃だけを行うと、一時的に改善したように見えても、内部から再び胞子が供給され、短期間で再発します。品質管理担当者から「同じ場所ばかり」という声をよく聞きますが、これは内部に原因が残っている典型例です。
MIST工法🄬カビバスターズ東京では、現地調査時にファイバースコープを用い、壁内や天井裏などの目視確認が困難な箇所を調査します。これにより、「見えないから問題ない」という思い込みを排除し、実際に何が起きているのかを可視化します。原因が内部にある場合、清掃や表面対策だけでは解決しないことを、調査段階で明確にすることが重要です。
数値で可視化する重要性|含水率・負圧・真菌検査
食品工場のカビ再発を本気で止めるために欠かせないのが、「感覚ではなく『数値による可視化』です。MIST工法🄬カビバスターズ東京では、現地調査において含水率検査を実施し、壁・床・天井などの建材がどの程度水分を含んでいるかを確認します。見た目が乾いていても、数値として高い含水率が出るケースは珍しくありません。
さらに、風量計を用いた負圧検査により、空気の流れや圧力差を確認します。これにより、胞子がどの方向から流入・滞留しているのかを把握できます。そして、一般社団法人微生物対策協会と連携した真菌検査(カビ菌検査)によって、空中や環境中のカビリスクを客観的に評価します。
これらを組み合わせることで、「なぜ再発するのか」「どこを改善すべきか」を論理的に説明できるようになります。品質管理担当者にとって重要なのは、説明責任を果たせる根拠を持つことです。数値とデータに基づく調査は、そのための強力な武器になります。
まとめ|関東エリアにある食品工場のカビトラブルでお悩みなら、まずは専門調査から
食品工場でカビが再発する原因は、決して「清掃不足」ではありません。
空中の胞子、結露、建材内部の湿気、空気の流れといった見えない原因が複雑に絡み合っています。これらは日常清掃だけでは把握・改善が難しく、放置すれば再発を繰り返すリスクが高まります。
MIST工法🄬カビバスターズ東京では、関東全域の食品工場を対象に、
・含水率検査
・ファイバースコープ調査
・風量計による負圧検査
・一般社団法人微生物対策協会と連携した真菌検査
を通じて、再発の根本原因を調査・可視化します。
「このカビ、また出るのではないか」
「清掃を続けても改善しない」
そう感じた時こそ、専門家にご相談ください。
カビの調査・検査・除去のご相談は、MIST工法🄬カビバスターズ東京まで。
品質管理の悩みを、根本から一緒に解決します。
■カビ検査・カビ調査・カビ取り・除菌などカビの事なら何でもお任せください■
-------カビ対策専門のカビバスターズ東京---------
対応エリア:東京・神奈川・千葉・埼玉・栃木・群馬・山梨・静岡・長野
お客様専用フリーダイヤル:0120-767-899
TEL:050-5527-9895 FAX:050-3131-0218
株式会社ワールド|カビバスターズ東京
【本社】〒152-0004 東京都目黒区鷹番1丁目1-5 フラットフォー本社ビル4F
【世田谷営業所】〒157-0067 東京都世田谷区喜多見2丁目5-1 PenthouseTB2F